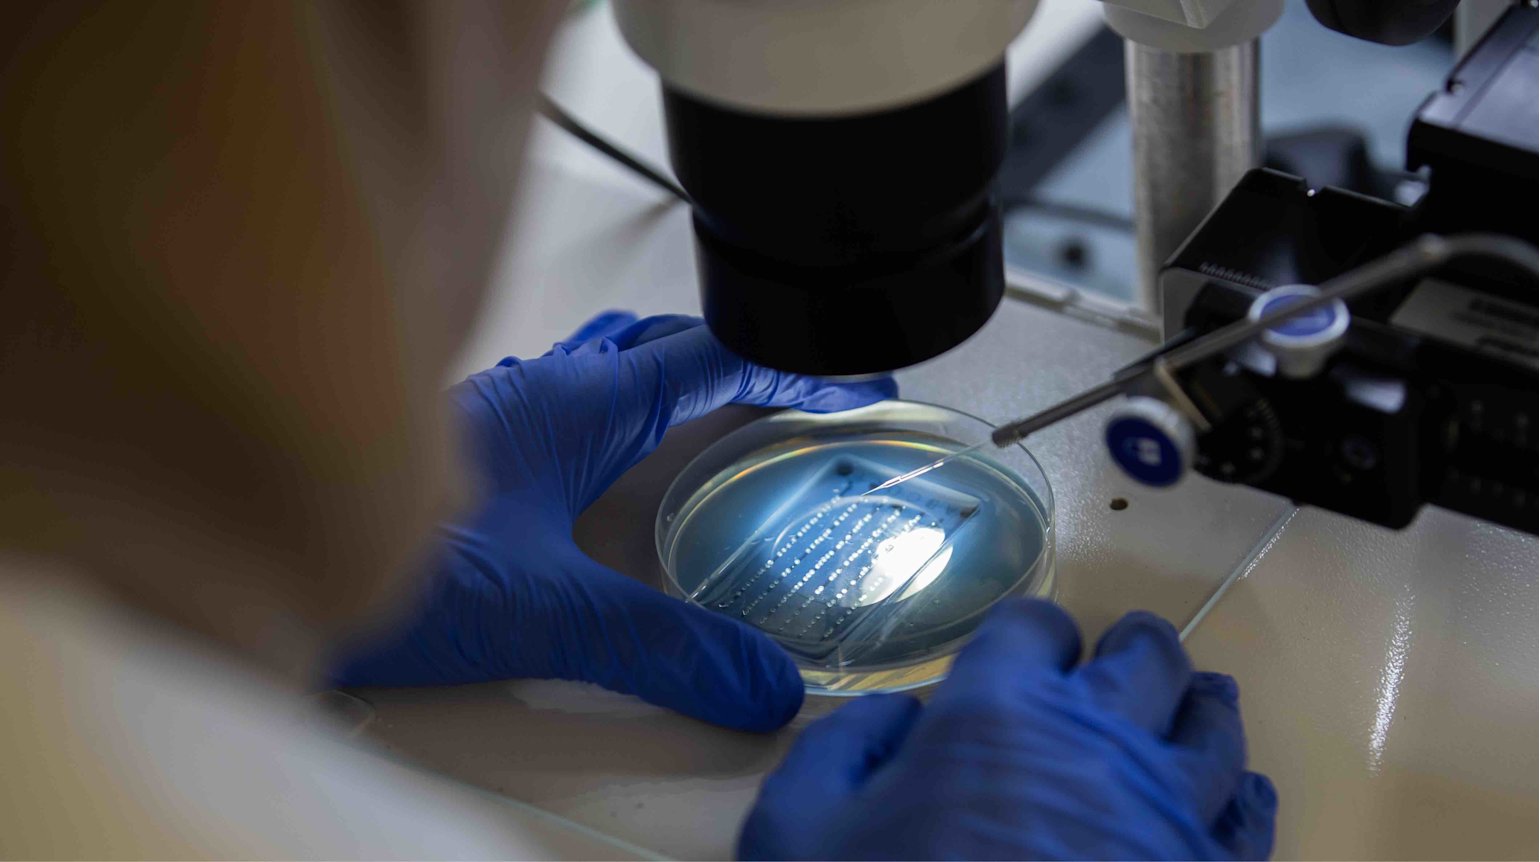
Using fish to diagnose diseases in humans - Sidra Medicine - - qf - 02

For the latest COVID-19 information and updates from Qatar Foundation, please visit our Statements page
Researchers at Sidra Medicine, a Qatar Foundation medical and research center, are working with zebrafish to understand human disease, particularly in children
A little-known fact is that several species of fish have genes that are extremely similar to those of humans. One such fish is the zebrafish. Small and unassuming, the zebrafish shares 70 percent of its genes with humans making it an ideal organism to help further our understanding of human genetics and diseases.
This is exactly what the Zebrafish Functional Genomics Facility at Qatar Foundation’s Sidra Medicine is currently working on. Using these small organisms, researchers are able to make connections between genetic variations and the diseases they cause.
When patients approach Sidra Medicine with unusual clinical presentation that leads to inconclusive diagnoses, they are referred for genetic testing. Although specific tests are conducted in the different clinics depending on the nature of their symptoms and suspected conditions; unsolved cases get referral for genetic testing.
The results of the genetic testing help identify some novel variants that have not been reported before. Knowing that a novel variant exists is not enough information to determine that it is the cause of a patient’s symptoms; so this data is provided to the zebrafish facility for research. The facility uses it to recreate a mini fish model of the patients’ genetic variation to study its relation to the disease.
Being able to recreate it in the zebrafish model, give us a better understanding of whether or not this really is the case. This allows for families to have a better understanding of what is happening
The facility currently conducts research primarily on rare pediatric conditions of congenital abnormalities, neurological disorders and cardiovascular diseases.
“When we find genetic mutation or variation, we cannot approach a patient’s family and tell them that this is the cause of their child’s disease, as we cannot be sure. Being able to recreate it in the zebrafish model, give us a better understanding of whether or not this really is the case. This allows for families to have a better understanding of what is happening, as well as for clinicians to decide which treatments or methods of management would be most effective,” said Dr. Sahar Da’as, Laboratory Manager at the Sidra Zebrafish Facility.
What makes zebrafish ideal for research like this – apart from easy accessibility and their small size – is that a large percentage of their genes also simulate human disease.
A specific case that stands out to Dr. Da’as is one where a child arrived at Sidra Medicine with a rare, complex neurological disorder that only has 50 reported cases worldwide. Upon detailing family history, doctors at Sidra Medicine found that the child’s mother had been complaining of reduced fetal movement while she was pregnant. This complaint had not been identified in any of the other cases. This allowed researchers to recreate the genetic variant found in the child in zebrafish model and look for this unique symptom.
Our goal at the moment is to understand the genetic mutations that present most commonly among the pediatric population
Sure enough, they found that when replicated in zebrafish, the variant caused brain abnormality, reduced motor skills and muscle movement at very early stages of development. While in this case, unfortunately, this did not offer much in the way of conclusive therapies, it did help clinicians understand the cause in order to advise the parents on how to manage future pregnancies and seek help early.
Sidra Medicine also uses zebrafish for research in pediatric diabetes, cancer, and cardiac disease. According to Dr. Da’as, the fish lend themselves well to research for a number of conditions. “Our goal at the moment is to understand the genetic mutations that present most commonly among the pediatric population. While we aim to conduct research on conditions and mutations that present in pregnant women and babies in-utero, we hope to also work on infertility issues in the future,” she said.